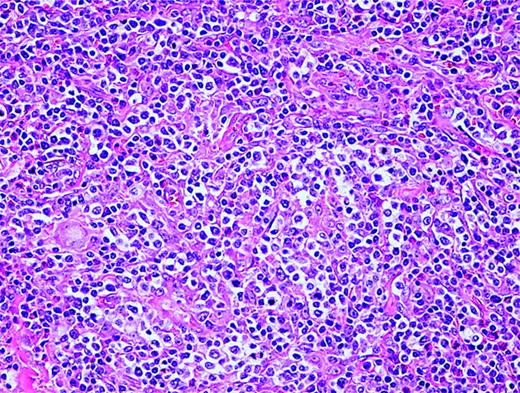
Figure 2. Angioimmunoblastic T-cell lymphoma. Many small vessels (high endothelial venules), histiocytes, scattered eosinophils, and plasma cells are admixed with the tumor cells that display clear cytoplasm.
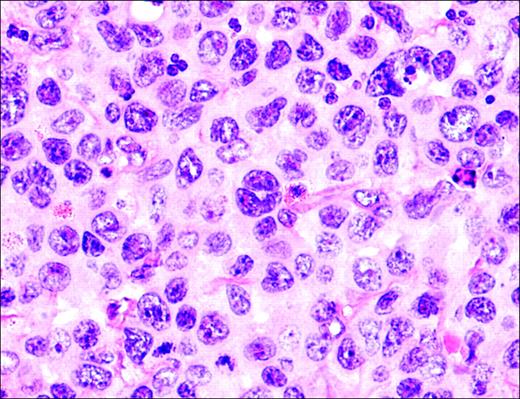
Figure 3. Anaplastic large-cell lymphoma. Infiltrate is composed of large transformed lymphocytes, including hallmark cells with kidney-shaped nuclei.

T-cell non-Hodgkin lymphomas (NHLs) are uncommon malignancies. The current WHO/EORTC classification recognizes 9 distinct clinicopathologic peripheral T-cell NHLs. These disorders have unique characteristics and require individualized diagnostic and therapeutic strategies. Tremendous progress has been made in recent years in the understanding of the pathogenesis of these disorders. Specific chromosomal translocations and viral infections are now known to be associated with certain lymphomas. In this review, we describe their clinical and pathologic features. We also discuss the use of molecular studies in the diagnostic work-up of T-cell lymphomas. Because of the rarity of these disorders and the lack of well-designed clinical trials, the treatment of peripheral T-cell NHLs is often challenging. Additional studies are required to learn more about the biology of these diseases, which may lead to more optimal and possibly targeted therapies.
Introduction
T-cell non-Hodgkin lymphomas (NHLs) are uncommon malignancies that represent approximately 12% of all lymphomas.1 Various geographic frequencies of T-cell NHL have been documented, ranging from 18.3% of NHLs diagnosed in Hong Kong to 1.5% in Vancouver, British Columbia, Canada. This may in part reflect increased exposure to pathogenic factors such as human T-cell leukemia virus-1 (HTLV-1) and Epstein-Barr virus (EBV) in Asian nations.2 T-cell NHL commonly presents with extranodal disease and often contains varying amounts of necrosis/apoptosis on biopsy specimens, making differentiation between a reactive process and lymphoma challenging. Immunophenotypic, cytogenetic, and molecular analyses have enhanced diagnostic capabilities and improved classification and prognostication for T-cell NHL.
The current World Health Organization/European Organization for Research and Treatment of Cancer (WHO/EORTC) classification recognizes 9 distinct clinicopathologic peripheral T-cell NHLs.3,4 The broad spectrum of pathologic subtypes with varied clinical behavior poses a challenge to the systematic study of these diseases. Furthermore, these distinct T-cell NHL subtypes have unique characteristics and often warrant individualized diagnostic and therapeutic treatment strategies. The primary cutaneous T-cell lymphomas were reviewed recently.4 We review herein the etiology, pathology, diagnosis, and treatment strategies for patients with peripheral T-cell lymphomas (Table 1).
Adult T-cell leukemia/lymphoma
The retrovirus HTLV-1 is critical to the development of adult T-cell leukemia/lymphoma (ATL).5 In endemic areas in Japan, approximately 6% to 37% of the population is infected with HTLV-1.6 The United States and Europe are considered low-risk areas; less than 1% of each population is seropositive.7 ATL develops in only 2% to 4% of patients who are carriers of the HTLV-1 virus.7 HTLV-1 is transmitted through sexual intercourse, blood products containing white blood cells, shared needles, breast milk, and vertically (ie, via childbirth).6 Transfusion of HTLV-1-contaminated blood products results in seroconversion in approximately 30% to 50% of patients at a median of 51 days.8
Subtypes
ATL is classified into 4 subtypes based on clinicopathologic features and prognosis: acute, lymphoma, chronic, and smoldering.10 In 1991, Shimoyama10 reported on the characteristics of 818 patients with ATL. Patients with the acute type had hypercalcemia, leukemia manifestations, tumor lesions, and the worst prognosis, with a median survival time of approximately 6 months. Patients with lymphoma had low levels of circulating abnormal lymphocytes (less than 1%) and nodal, liver, splenic, central nervous system, bone, and gastrointestinal disease and had a median survival time of 10 months. Patients with the chronic type had more than 5% abnormal circulating lymphocytes and a median survival time of 24 months, whereas the median survival time of patients with the smoldering type had not yet been reached.
Pathology
Abnormal T-lymphocytes are often seen in the peripheral-blood smear. The cells have indented or lobulated nuclei suggesting the term flower cells (Figure 1). HTLV-1 is a single-stranded, diploid RNA virus that integrates into the host DNA.11 HTLV-1 encodes 3 structural genes (pol, gag, and tax) and 2 regulatory genes (tax and rex). Tax, a potent HTLV-1 transcription activator, plays an important role in HTLV-1-induced transformation and resistance to apoptosis, in part through the activation of the NF-κB pathway.12 Adult T-cell leukemia cells often express CD3, CD4, CD25, and CD52 antigens.
Molecular genetics
Itoyama et al13 examined the cytogenetic abnormalities in 50 patients with newly diagnosed ATL.13 All 50 patients had abnormal karyotypes, and almost all chromosomes were affected. Multiple chromosomal breaks (more than 6) and aneuploidy were significantly more frequent in patients with the combined acute and lymphoma subtypes than in those with chronic ATL. Moreover, multiple chromosomal breaks (more than 6) and abnormalities of 1p, 1p22, 2q, 3q, 14q, and 14q32 were associated with worse overall survival (OS). Gains in 1q and 4q were significantly more common in patients with aggressive ATL, whereas a gain of 7q was associated with good prognosis within the group of patients with aggressive disease.14 The T-cell receptor genes are clonally rearranged, and there is evidence of clonal integration of HTLV-1.15,16
Treatment
ATL is a difficult malignancy to treat. Patients may initially respond to combination chemotherapy, but OS is poor (median, 8 months).6 Response rates of 70% to 90% to combination IFN-α and zidovudine therapy have been demonstrated in ATL with associated median survival rates of 11 to 18 months.17,18 A recent clinical trial that investigated initial cytoreductive therapy with cyclophosphamide, doxorubicin, vincristine, and prednisone (CHOP), followed by antinucleoside, IFN-α, and oral etoposide therapy, demonstrated encouraging results.19 El-Sabban et al20 combined arsenic trioxide (As2O3) with IFN-α, which induced cell-cycle arrest and apoptosis. Bazarbachi et al21 corroborated these data, as they demonstrated high synergy between IFN-α and As2O3 with respect to cellular proliferation, cell-cycle arrest, and induction of apoptosis in HTLV-1-transformed cell lines and primary ATL cells in culture.21,22 Proteasome inhibitors and all-trans retinoic acid (ATRA) have also been shown to have an effect on ATL cell-cycle progression, which may have implications for the clinical application of these agents in ATL.23,24 Future research should include the investigation of monoclonal antibodies, such as denileukin diftitox and alemtuzumab (Campath-1H).
Peripheral T-cell lymphoma, unspecified (PTCL-u)
PTCL-u is predominantly a nodal lymphoma that represents the most common T-cell lymphoma subtype in Western countries. Rudiger et al2 noted that it comprises approximately 60% to 70% of T-cell lymphomas and 5% to 7% of all NHLs. PTCL-u usually affects adults (male-female ratio, 1.5) at a median age of 61 years (range, 17-90 years). In that study,2 27% of patients presented with stage I or IIE disease, 12% had stage III disease, and 61% had stage IV disease. Patients with PTCL-u commonly have unfavorable characteristics, including B symptoms, elevated LDH levels, bulky tumor measuring 10 cm or greater, nonambulatory performance status, and extranodal disease leading to most (53%) patients falling into the unfavorable International Prognostic Index (IPI) category (score of 3-5). In a recent report, multivariate analysis showed that the IPI was a better predictor of survival than the histologic subtype of mature T-cell lymphoma.25
Pathology
Earlier studies of peripheral T-cell NHL recognized a variety of morphologic subtypes based on cell size: diffuse small cleaved, mixed cell, large cell, and immunoblastic. In addition, lymphoepithelioid (Lennert) lymphoma is considered a cytopathologic variant rich in epithelioid cells. However, reliable histologic definitions based on these morphologic subtypes have not been defined. Moreover, no clinical differences have been demonstrated based on these varied histologic subgroups.2 T-cell-associated antigens such as CD3, CD5, and CD7 are variably expressed on immunophenotypic analysis, although one of the mature T-cell antigens (CD5 or CD7) is usually lost. Furthermore, CD4 is more commonly expressed than CD8.
Molecular genetics
Ninety percent of patients with PTCL-u have clonally rearranged TCR genes.26 The gamma locus is more frequently rearranged whatever the TCR expression; therefore, analysis of γ TCR loci may provide a higher diagnostic yield.27 Overall, cytogenetic aberrations in PTCL-u are common, with approximately 70% to 90% of abnormal metaphases documented in most series.28,29 Schlegelberger and Feller29 reported that chromosome analysis in PTCL-u allowed for the separation of PTCL-u into low- and high-grade categories, but the prognostic significance of this distinction has not been established.
A Japanese study30 documented p53 gene mutations in 5 of 5 patients with peripheral T-cell lymphoma after renal transplant. This study also demonstrated that 25% of patients had k-ras mutations and that 33.3% of patients had mutations of c-kit and β-catenin genes. Furthermore, compared with p53-negative patients, p53-positive patients have been shown to have significantly higher proliferative activity, less frequent expression of the downstream p21(Waf1) protein, and frequent expression of Bcl-2.31 Prognostic studies in PTCL-u have demonstrated that p53 protein overexpression and mutation of p53 correlate significantly with treatment failure and worse overall and disease-free survival.31-33
Adult T-cell leukemia/lymphoma. Peripheral blood illustrates 2 lymphoma cells. One displays a lobated nucleus with clumped chromatin; the other is larger with more dispersed chromatin and a cerebriform-shaped nucleus.
Adult T-cell leukemia/lymphoma. Peripheral blood illustrates 2 lymphoma cells. One displays a lobated nucleus with clumped chromatin; the other is larger with more dispersed chromatin and a cerebriform-shaped nucleus.
Treatment
Randomized trials comparing cyclophosphamide, hydroxydaunomycin, Oncovin, prednisone (CHOP) with other combination regimens confirm CHOP as a standard regimen for intermediate-grade B-cell NHL, although these trials do not allow for subset analysis of T-cell patients.34,35 Rituximab should not be included in the treatment for PTCL-u unless other conditions, such as immune thrombocytopenic purpura, exist.
Nucleoside analogs, such as 2′-deoxycoformin (dCF; pentostatin), fludarabine, and 2-chlorodeoxyadenosine (2-CdA), have been evaluated, mainly in patients with cutaneous NHL, though several anecdotal reports have reported activity in other T-cell NHL subytpes.36,37 The response rate to pentostatin is variable, ranging from 15% to 100% in patients with PTCL-u.37-39 Gemcitabine has activity in patients with relapsed/refractory T-cell NHL as a single agent, with response rates of 60% in small, single-institution studies.40,41
Denileukin diftitox (Ontak), a recombinant fusion protein consisting of peptide sequences of diphtheria toxin and recombinant interleukin-2 receptor (CD25), has been studied mostly in cutaneous T-cell NHL, though clinical benefit has also been reported in patients with other types of T-cell NHL.42,43 Preliminary data from a phase 2 trial with single-agent denileukin diftitox showed a 40% overall response rate in patients with relapsed/refractory PTCL-u.44 A recent European pilot study showed a 36% response rate with alemtuzumab in heavily pretreated PTCL-u patients. Three of 14 patients had a complete remission (CR) that lasted up to 12 months. However, significant hematologic and infectious complications occurred.45
Angioimmunoblastic T-cell lymphoma
Angioimmunoblastic T-cell lymphoma (AITL), also known as angioimmunoblastic lymphadenopathy with dysproteinemia, is one of the more common T-cell lymphomas, accounting for 15% to 20% of cases and 4% to 6% of all lymphomas.2 Median age at presentation is 64 years, with a slight male predominance; most patients present with stage III or IV disease.46 AITL is commonly a systemic disease with nodal involvement and various associated disease features such as organomegaly, B symptoms (50%-70%), skin rash, pruritus, pleural effusions, arthritis, eosinophilia, and a spectrum of immunologic abnormalities.46
Pathology
AITL is characterized by a polymorphous infiltrate of lymph nodes with the normal nodal architecture commonly effaced with opened and dilated peripheral sinuses. There is often significant proliferation of high endothelial venules and follicular dendritic cells (Figure 2). The lymphoid cells commonly consist of a mixture of small and medium-sized lymphocytes with plasma cells and B-immunoblasts, while clusters of epithelioid histiocytes and many eosinophils may be present. T-cell-associated antigens are usually expressed, with CD4 expression more common than CD8 expression.
Angioimmunoblastic T-cell lymphoma. Many small vessels (high endothelial venules), histiocytes, scattered eosinophils, and plasma cells are admixed with the tumor cells that display clear cytoplasm.
Angioimmunoblastic T-cell lymphoma. Many small vessels (high endothelial venules), histiocytes, scattered eosinophils, and plasma cells are admixed with the tumor cells that display clear cytoplasm.
Molecular genetics
Histologic diagnosis of AITL may be difficult; therefore, demonstration of TCR clonality is often important for diagnosis. Feller et al47 documented that specific patterns of clonal gene rearrangement correlate with prognosis inAITL. In their study, 47 patients with concomitant TCR β-chain gene and immunoglobulin gene rearrangements often presented with hemolytic anemia and experienced spontaneous transient remissions but did not respond as well to chemotherapy and had worse OS than patients with “TCR-only” clonality. Some histologic cases of AITL may demonstrate oligo-clonality, whereas others may show regression or appearance of clonality.48
Conventional cytogenetics (metaphase analysis) will detect chromosomal abnormalities in approximately 70% to 80% of patients with AITL.28,29 One study incorporating interphase cytogenetic (fluorescence in situ hybridization [FISH]) analysis increased the number of aberrant chromosomes identified to 90% of patients, and more than 40% of patients were noted to have varied T-cell populations.49 Trisomy 3 and 5 and an additional X chromosome are the most frequent cytogenetic abnormalities detected in patients with AITL.49 The presence of a complex karyotype was associated with inferior survival.50
B-cell EBV genomes are detected by polymerase chain reaction (PCR) or FISH analysis in up to 100% of AITL-involved lymph nodes.51 The exact role of EBV in the pathogenesis ofAITL is unknown, though recent research demonstrates significant interplay between AITL and the survival and clonal expansion of EBV.51,52
Treatment
AITL typically follows an aggressive clinical course; spontaneous regression occurs on rare occasions. Treatment with anthracycline-based combination chemotherapy results in complete remission (CR) rates of 50% to 70%, but only 10% to 30% of patients are long-term survivors.53,54 In one prospective, nonrandomized, multicenter study of patients with newly diagnosed stable AITL, patients were treated with single-agent prednisone, whereas patients presenting with life-threatening disease or relapsed/refractory disease received combination chemotherapy.55 The CR rate was 29% with single-agent prednisone, whereas CR rates for relapsed/refractory patients or patients treated initially with combination chemotherapy were 56% and 64%, respectively. With a median follow-up of 28 months, the OS and disease-free survival (DFS) rates were 40.5% and 32.3%, respectively, though median OS was 15 months.55 There are anecdotal reports of patients with relapsed AITL who have responded to immunosuppressive therapy, such as low-dose methotrexate/prednisone and cyclosporine, purine analogs, and denileukin diftitox.44,56,57
Anaplastic large-cell lymphoma. Infiltrate is composed of large transformed lymphocytes, including hallmark cells with kidney-shaped nuclei.
Anaplastic large-cell lymphoma. Infiltrate is composed of large transformed lymphocytes, including hallmark cells with kidney-shaped nuclei.
Anaplastic large-cell lymphoma, T/null cell, primary systemic type
Anaplastic large-cell lymphoma (ALCL), primary systemic type, accounts for approximately 2% to 3% of all NHLs.58 This disease mainly affects lymph nodes, although extranodal sites may be involved. ALCL may be divided in part based on the expression of the tyrosine kinase anaplastic lymphoma kinase (ALK). When heterogeneous patient populations are analyzed, the prevalence of ALK positivity in patients with primary systemic ALCL is 50% to 60%.59,60 ALK-positive ALCL is typically diagnosed in men before age 35 (male-female ratio, 3.0) with frequent systemic symptoms, extranodal disease, and advanced-stage disease.60 ALK-negative patients are usually older (median age, 61 years), with a male-female ratio of 0.9, and are less likely to present with extranodal disease.60 The determination of ALK positivity is important because it denotes a significant favorable prognosis, with reported 5-year OS rates of 79% in contrast to 46% for patients with ALK-negative ALCL.59 Moreover, the prognosis for ALK-positive and ALK-negative ALCL may be further divided based on CD56 positivity (neural cell-adhesion molecule), which portends a significantly worse outcome when it is expressed in either ALCL subgroup.61
Pathology
The morphology of ALCL, systemic type, consists of large lymphoid cells with pleomorphic or multiple prominent nuclei and abundant cytoplasm (Figure 3). Tumor cells grow in a cohesive pattern, and there is often sinusoidal spread in the lymph nodes. Tumor cells express CD30 and either T cell or no specific lineage antigens (null cell).
Molecular genetics
PCR analysis for TCR rearrangements have demonstrated clonal rearrangements in most (70-90%) patients with T-cell and null-type ALCL, with clonal β genes more commonly detected than γ gene rearrangements.62 In 1988 it was demonstrated that ALCL is associated with the chromosome translocation t(2;5)(p23;q35).63 This nonrandom t(2;5) chromosome translocation has been cloned and is known to cause the fusion of the nucleophosim (NPM) gene located at 5q35 to the gene at 2p23 encoding the receptor tyrosine kinase ALK, resulting in the fusion protein NPM-ALK.64 The transcription of the 80-kDa chimeric fusion protein NPM-ALK results as a consequence of the ALK gene coming under the control of the NPM promoter.65 The presence of NPM-ALK may be detected by reverse transcription-polymerase chain reaction (RT-PCR) and FISH techniques.66,67 Polyclonal (ALK11) and monoclonal (ALK1 and ALKc) antibodies specific for the ALK portion of the molecule have been established that stain both the cytoplasm and the nucleus in tissues containing the NPM-ALK translocation.68 As many as 20% of ALK-positive patients with ALCL are found to be negative for the t(2;5) translocation.69 Other fusion partners to the ALK gene include nonmuscle tropomyosin (TPM3) forming t(1;2)(q21;p23) and creating the chimeric protein TPM3-ALK,70 tropomyosin receptor kinase-fused gene (TFG) forming t(2;3)(p23;q21) and resulting in the TFG-ALK protein,71 clathrin heavy polypeptide-like gene (CLTCL) forming t(2;22)(p23;q11) and resulting in the CLTCL-ALK protein,72 and 5-aminoimidazole-4-carboxamide ribonucleotide-transformylase/inosine-monophosphate-cyclohydrolase enzymatic activities (ATIC) caused by inversion (2)(p23;q35) and resulting in ATIC-ALK73 (Table 2).74
Other mechanisms of oncogenesis in ALCL include increased bcl-2,75 hypermethylation,76 and c-myc expression.77 Furthermore, the NPM/ALK fusion protein constitutively activates the phosphatidylinositol 3-kinase (PI3K)-Akt pathway, suggesting that this pathway may be involved in the molecular pathogenesis of ALCL.78
Treatment
Therapy for pediatric ALCL is often based on prognostic risk factors, with treatment regimens modeled after high-grade B-cell NHL protocols. After a brief cytoreductive prephase, short, intensified polyagent chemotherapy is administered, with the number of cycles depending on the stage of disease.79 Therapy for adult ALCL, systemic type, has commonly included anthracycline-based regimens.80 Autologous hematopoietic stem cell transplantation (HSCT) in first complete remission has been advocated by some groups, though this approach warrants prospective validation.
Subcutaneous panniculitis-like T-cell lymphoma
Subcutaneous panniculitis-like T-cell lymphoma (SCPTCL) is a rare T-cell lymphoma that primarily infiltrates the subcutaneous fat without dermal or epidermal involvement, causing erythematous to violaceous nodules, plaques, or both. It is often associated with a systemic hemophagocytic syndrome and is characterized by high fever, skin lesions, lung infiltrates, jaundice, hepatosplenomegaly, liver dysfunction, coagulation abnormalities, pancytopenia, and a benign prominent histiocytic proliferation with hemophagocytosis. The hemophagocytic syndrome associated with T-cell neoplasms can occur before, during, or while the disease is in remission.81,82 Moreover, a controversial entity known as cytophagic histiocytic panniculitis (CHP) has been described as an inflammatory disease with a possible association to SCPTCL.83 CHP has been recognized to have diverse outcomes ranging from indolent to aggressive/fatal clinical courses.83 In the recent WHO/EORTC classification, only cases with an αβ phenotype are classified as SCPTCL. Cases previously classified as SCPTCL with a γδ phenotype, which comprised of 25% of all cases, are now classified as cutaneous γδ T-cell lymphomas.4 SCPTCL has a more indolent course and is less likely to be associated with the hemophagocytic syndrome than cutaneous γδ T-cell lymphomas.4,84
Pathology
SCPTCL is a rare T-cell lymphoma localized to subcutaneous tissue consisting of a mixture of small, medium, and large atypical cells with prominent tumor necrosis and karyorrhexis. The neoplastic lymphocytes often rim individual adipocytes (Figure 4). Benign/reactive histiocytes may be present with associated phagocytosis of red cells or nuclear debris. Necrosis of fat and connective tissue is always seen, but not with angiodestruction.
Molecular genetics
PCR gene rearrangement studies have recently demonstrated that CHP is likely part of the same clinicopathologic spectrum as SCPTCL, with SCPTCL representing a neoplastic clonal process and CHP representing premalignant lymphoid disease.82,83,85 Most reports demonstrate a monoclonal TCR, and many patients are EBV positive. Retrospective case series with larger patient numbers have corroborated the clonality of TCR in most patients with SCPTCL but have not validated an association with EBV.82 Chromosome abnormalities and proto-oncogenes associated with SCPTCL are reported rarely in the literature.
Treatment
The clinical course of SCPTCL is variable, ranging from indolent disease to rapidly fatal fulminant hemophagocytosis.82,86 When treatment is warranted, most patients respond to systemic combination chemotherapy or local radiation therapy, though median survival time is typically less than 2 years.86 Recent studies, with more accurate phenotypic analysis, show that the αβ phenotype may actually have a 5-year survival rate of 80%.87
Cutaneous γδ T-cell lymphoma
Cutaneous γδ T-cell lymphoma (CGD-TCL) includes lymphomas previously classified as SCPTCL with a γδ phenotype.4 CGD-TCL has a more aggressive course than SCPTCL. Patients present with skin lesions similar to those of SCPTCL, but they may have epidermal and dermal involvement. Patients with subcutaneous disease do worse than those with only epidermotropic or dermal disease.87 Patients with CGD-TCL may also have mucosal involvement.88 It is still debated whether cutaneous lymphoma and mucosal γδ lymphoma are 2 different diseases or are different presentations of the same disease. Hemophagocytic syndrome can occur with CGD-TCL, but generally patients do not have evidence of systemic disease on presentation.88,89
Pathology
Three histologic patterns are present in the skin: epidermotropic, dermal, and subcutaneous. A single biopsy specimen may contain more than one histologic type. The cells are medium to large and have features of angiocentrism, angioinvasion, epitheliotropism, and necrosis. There may be rimming of adipocytes as in SCPTCL. Arnulf et al88 showed that 5 of 11 patients with nonhepatosplenic γδ T-cell lymphomas were positive for EBV by immunohistochemistry using Epstein-Barr virus-encoded ribonucleic acid (EBER) probes. Three of the patients had nasal mucosa involvement. Whether EBV plays a role in the pathogenesis of CGD-TCL is still questionable.
Molecular genetics
No specific chromosomal abnormalities are seen in patients with CGD-TCL. The TCR is clonally rearranged.
Subcutaneous panniculitis-like T-cell lymphoma. (A) Infiltrate involves the subcutaneous tissues and spares the dermis and epidermis. (B) Lymphoma cells are variably sized, ranging from small to large cells with pleomorphic, hyperchromatic nuclei. (C) CD3 immunohistochemical stain highlights the tumor cells, including those rimming individual fat cells.
Subcutaneous panniculitis-like T-cell lymphoma. (A) Infiltrate involves the subcutaneous tissues and spares the dermis and epidermis. (B) Lymphoma cells are variably sized, ranging from small to large cells with pleomorphic, hyperchromatic nuclei. (C) CD3 immunohistochemical stain highlights the tumor cells, including those rimming individual fat cells.
Hepatosplenic T-cell lymphoma involving the bone marrow. (A) Tumor cells in the bone marrow aspirate resemble blasts. They are medium-sized with dispersed chromatin and scant cytoplasm. (B) Two lymphoma cells display erythrophagocytosis. (C) Hypercellular bone marrow with almost all normal hematopoietic cells replaced by lymphoma cells growing in sheets. (D) Lymphoma cells located within the lumen of a sinus.
Hepatosplenic T-cell lymphoma involving the bone marrow. (A) Tumor cells in the bone marrow aspirate resemble blasts. They are medium-sized with dispersed chromatin and scant cytoplasm. (B) Two lymphoma cells display erythrophagocytosis. (C) Hypercellular bone marrow with almost all normal hematopoietic cells replaced by lymphoma cells growing in sheets. (D) Lymphoma cells located within the lumen of a sinus.
Treatment
Patients are usually treated with aggressive regimens.88,89 Toro et al89 treated patients with local therapies such as topical steroids, psoralen, and psoralen plus ultraviolet light of A wavelength (PUVA) radiation and with systemic therapies such as interferon-α, interferon-γ, CHOP, radiation therapy, and bone marrow transplantation. Patients with dermal and epidermotropic involvement had a median survival time of 29 months. Patients with subcutaneous disease had a less favorable median survival time of 13 months.
Hepatosplenic T-cell lymphoma
Hepatosplenic T-cell lymphoma (HSTCL) is an uncommon T-cell lymphoma that is seen mainly in young males (median age, 35 years). Patients have B symptoms, prominent hepatosplenomegaly, anemia, neutropenia, thrombocytopenia (commonly severe), peripheral-blood lymphocytosis, and lymphadenopathy. It is often associated with an aggressive clinical course (median survival, 16 months).90
Pathology
HSTCL infiltrates the sinuses of the liver, bone marrow (two thirds of patients), and splenic red pulp. HSTCL tumor cells are usually homogeneous, medium-sized lymphoid cells with round nuclei, moderately condensed chromatin, and pale cytoplasm. Erythrophagocytosis may be present in the spleen and bone marrow, and circulating peripheral-blood tumor cells are seen in approximately 25% to 50% of patients (Figure 5). TIA-1 is almost always present, but commonly granzyme B and perforin are not present, indicating a nonactivated cytotoxic T-cell phenotype. Tumor cells are usually CD4-, CD5-, and CD8- and CD3+, CD7+, and CD56+.
Molecular genetics
HSTCL likely arises from γδ T cells of the hepatic sinusoids and splenic red pulp, and most patients with HSTCL demonstrate a clonal TCR γ-gene or δ-gene rearrangement.91,92 An αβ T-cell phenotype has been described in HSTCL.93 The primary recurrent chromosome abnormality in HSTCL is isochrome 7q, although not all series have documented i(7q) abnormalities in HSTCL.90
Treatment
The clinical course of HSTCL is usually aggressive despite multiagent chemotherapy.90 Anecdotal reports have described activity with the purine analog pentostatin in relapsed disease.94 In a recent case report, a patient with αβ HSTCL was treated with alemtuzumab and the patient subsequently underwent unmatched, unrelated stem-cell transplantation. The patient was alive with no evidence of disease after almost 21 months of follow-up.95
Extranodal NK/T-cell lymphoma, nasal and nasal-type
Extranodal NK/T-cell lymphoma, nasal and nasal-type, formerly known as angiocentric lymphoma, is rare in Western countries and is more prevalent in Asia and in South and Central America.96 The disease commonly manifests in men at the median age of 43. It is associated with EBV and is typically characterized by extranodal presentation and localized stage I/II disease, but with angiodestructive proliferation and an aggressive clinical course.97-99 These tumors have a predilection for the nasal cavity and paranasal sinuses (nasal), although the nasal-type designation encompasses other extranodal sites of NK/T-cell lymphomatous disease (skin, gastrointestinal, testis, kidney, upper respiratory tract, and rarely orbit/eye).
Pathology
Extranodal NK/T-cell lymphoma is designated NK/T secondary to the uncertainty of its cellular origin. The characteristic histologic feature is an angiodestructive pattern with frequent necrosis. Tumor cells consist of a mixture of small, medium, and large cells, but most are large dysplastic cells. The cells often express NK antigens (CD16, CD56, CD57), cytoplasmic CD3, and cytotoxic granules (granzyme B and TIA-1).
Molecular genetics
The rearrangement of TCR genes has been inconsistently identified in extranodal NK/T-cell lymphoma.100,101 When present, γδ rearrangements are more common. Studies have suggested that separation into distinct NK-cell and T-cell categories is feasible based on lineage-specific TCR rearrangements and immunophenotype.101 Cytogenetic abnormalities are common in extranodal NK/T-cell lymphoma, nasal type. Siu et al102 found deletions of chromosome 6—del(6)(q16-q27)—and chromosome 13—del(13)(q14-q34)—to be the most frequent cytogenetic abnormalities.
Identifying oncogenes related to extranodal NK/T-cell lymphoma has been difficult, in part related to the sufficient recovery of viable, nonnecrotic tissue for appropriate analyses. p53 has been shown to be overexpressed in many patients with extranodal NK/T-cell lymphoma, nasal type.99 Mutations of k-ras have been described in this lymphoma.30 Homozygous deletions of the p15, p16, and p14 genes have been documented in nasal NK lymphoma.103 EBV may play a role in the oncogenesis of extranodal NK/T-cell lymphoma, nasal type. EBER-1 RNA transcripts are detectable in most cells in nearly all patients.100,104 Moreover, EBV-latent membrane protein (LMP-1) is expressed in most patients.104
Treatment
Combined modality therapy incorporating adriamycin-based chemotherapy, involved-field (IF) radiation,98 and intrathecal prophylaxis is recommended for patients with extranodal NK/T-cell lymphoma, nasal type. The benefit of adding chemotherapy to radiation has not been confirmed for limited-stage disease.97 Response rates for NK/T-cell lymphoma, nasal type, have been reported to be near 85% (66% CR) after radiation alone, although 50% of patients experience local relapse and 25% of patients experience systemic relapse with a predilection to extranodal sites such as testis, orbit, skin, gastrointestinal tract, and central nervous system.105 Kim et al105 showed that after a median follow-up of 56 months, the OS rate for patients with stage I and II disease was 40%. Systemic relapse was rapidly fatal.105 Li et al106 recently reported on 77 patients with NK/T-cell sinonasal lymphoma (56 locoregional, 21 systemic disease) with a 5-year OS rate of 36% (median follow-up, 89 months). Combined chemotherapy/radiation or radiation alone resulted in better survival than chemotherapy alone (5-year survival rates, 59%, 50%, and 15%, respectively; P = .01).
Enteropathy-type intestinal T-cell lymphoma
Enteropathy-type intestinal T-cell lymphoma (EITCL), also known as intestinal T-cell lymphoma, is a rare T-cell lymphoma of intraepithelial lymphocytes that commonly presents with multiple circumferential jejunal ulcers in adults. Patients usually have a prior brief history of gluten-sensitive enteropathy.108 EITCL accounts for less than 1% of NHLs and has been recognized to have a poor prognosis, with reported 5-year OS and disease-free survival rates of 20% and 3%, respectively.108 This is in part related to many patients presenting with poor performance status.
EITCL may manifest without antecedent history of celiac disease, but most patients have abdominal pain and weight loss. Evidence of serologic markers for celiac disease, such as positive antigliadin antibodies and HLA types (DQA1*0501/DQB1*0201/DRB1*0304), may be present at diagnosis.109 Moreover, these genotypes may represent patients with celiac disease at higher risk for EITCL.109 Small bowel perforation or obstruction, gastrointestinal bleeding, and enterocolic fistulas are recognized complications of this disease.108
Pathology
EITCL may be a difficult diagnosis to establish on histologic grounds alone. The tumor cells contain a combination of small, medium, and large (anaplastic) cells, and reactive histiocytes are often seen. The immunophenotype consists of pan-T-cell antigens, and the mucosal lymphoid antigen CD103 is often expressed.
Molecular genetics
The TCR genes are rearranged in nearly all patients with EITCL (more commonly γ than β).110,111 Obermann et al112 recently found loss of heterozygosity at chromosome 9p21 to be associated with EITCL. One report documented that 9 of 19 patients had collections of small lymphocytes in the affected bowel expressing p53.110 The role of p53 in the oncogenesis of EITCL is not known. Various reports have documented EBV positivity (by PCR and FISH) in association with EITCL, including EBV-related EITCL PTLD.113,114 Furthermore, analysis comparing the prevalence of EBV in Mexican and European patients with EITCL demonstrated significant epidemiologic differences in EBV association (100% vs 10%, respectively).114
Treatment
Adriamycin-based combination chemotherapy should be considered for each patient with a diagnosis of EITCL; aggressive nutritional support with parenteral or enteral feeding is critical.108 Patients with known celiac disease should adhere to a gluten-free diet.
Hematopoietic stem cell transplantation
The exact role of autologous or allogeneic HSCT in T-cell NHL has not been defined. Several case series have reported the outcomes of patients with relapsed T-cell NHL after autologous and allogeneic HSCT.115-120 PTCL-u and ALCL were the predominant subtypes in these trials, and the 3-year OS rates ranged from 36% to 58% after autologous HSCT (median follow-up, 36-43 months).115,117 High IPI score (2 or greater) significantly predicted a worse outcome in one of the above-described trials117 but not in the other.115 Furthermore, ALCL (vs non-ALCL) predicted an improved outcome in the largest trial (3-year OS rate, 79% vs 44%, respectively; P = .081).
Song et al118 recently compared relapsed/refractory T-cell NHL with diffuse large B-cell lymphoma (DLBCL) in patients who underwent autologous HSCT over a 12-year period. Thirty-six patients with relapsed or primary refractory T-cell NHL were compared with 97 patients with relapsed DLBCL. With a median follow-up of 42 months, 3-year OS rates were 48% in patients with T-cell NHL and 53% in patients with DLBCL. They documented no significant outcome differences according to T-cell subtype, although PTCL-u patients had a trend for inferior 3-year disease-free survival. Rodriguez et al121 recently showed that patients with T-cell NHL who do not achieve CR after initial chemotherapy may experience long-term survival when salvaged with autologous HSCT.
HSCT in first remission remains controversial. French and Italian investigators have documented long-term survival rates of approximately 90% for ALCL patients who underwent autologous HSCT in first CR.122,123 These results are encouraging, but patients with systemic ALCL (especially ALK-positive) have the best prognosis among those with T-cell NHL subtypes. Prospective, randomized trials must be performed to confirm these observations, especially in patients at higher risk. Small case series and anecdotal reports have described the feasibility and long-term survival for matched-sibling and unrelated allogeneic HSCT for patients with chemotherapy-resistant T-cell NHL and patients with hemophagocytic syndrome.116,117,124
Radiation therapy
Because of the paucity of clinical trials, the integration of radiation therapy into the treatment plan of most patients with T-cell NHL often models that of patients with B-cell NHL. Compared with patients with DLBCL, those with T-cell NHL more commonly present with stage III and IV disease (48% and 74%, respectively),58 and T-cell patients frequently present with combined nodal and extranodal disease at diagnosis (especially PTCL-u, ALCL, and AIL), thereby often obviating the need for the addition of radiation. Studies specifically addressing the benefits of radiation therapy to bulky sites for patients with advanced T-cell NHL have not been performed.
Emerging therapies
Relevant proto-oncogenes and tumor-suppressor genes involved in the pathogenesis of T-cell NHL represent potential candidates for molecular-based therapy. Gene therapy using adenoviral vector-mediated wild-type p53 gene transfer is being evaluated and may have application in certain T-cell lymphomas.125 In addition to denileukin diftitox, several other recombinant chimeric immunotoxins have been successfully produced, such as the anti-CD30 antibody combined with a mutant Pseudomonas exotoxin.126 A monoclonal antibody directed against the human transferrin receptor (TfR) in HTLV-1-infected cells (mAb A24) is under development.127 Protein kinase C-modulating agents UCN-01 and bryostatin are also being studied.128,129 Furthermore, histone deacetylase (HDAC) inhibitors (such as depsipeptide and SAHA) increase histone acetylation leading to cellular differentiation, decreased cell proliferation, and induction of cell death and are being examined in patients with T-cell NHL.130 The role of viral pathogenesis in T-cell NHL tumor development continues to be studied as a potential target of drug therapy.
Continuing research is needed to allow more accurate prediction of disease course and to further elucidate the molecular oncogenesis of T-cell NHL. Prospective, multi-institution clinical trials remain critically important for determining the most effective treatment regimens that will continue to improve cure rates in these aggressive yet treatable, and often curable, diseases.
Prepublished online as Blood First Edition Paper, October 6, 2005; DOI 10.1182/blood-2005-03-1306.